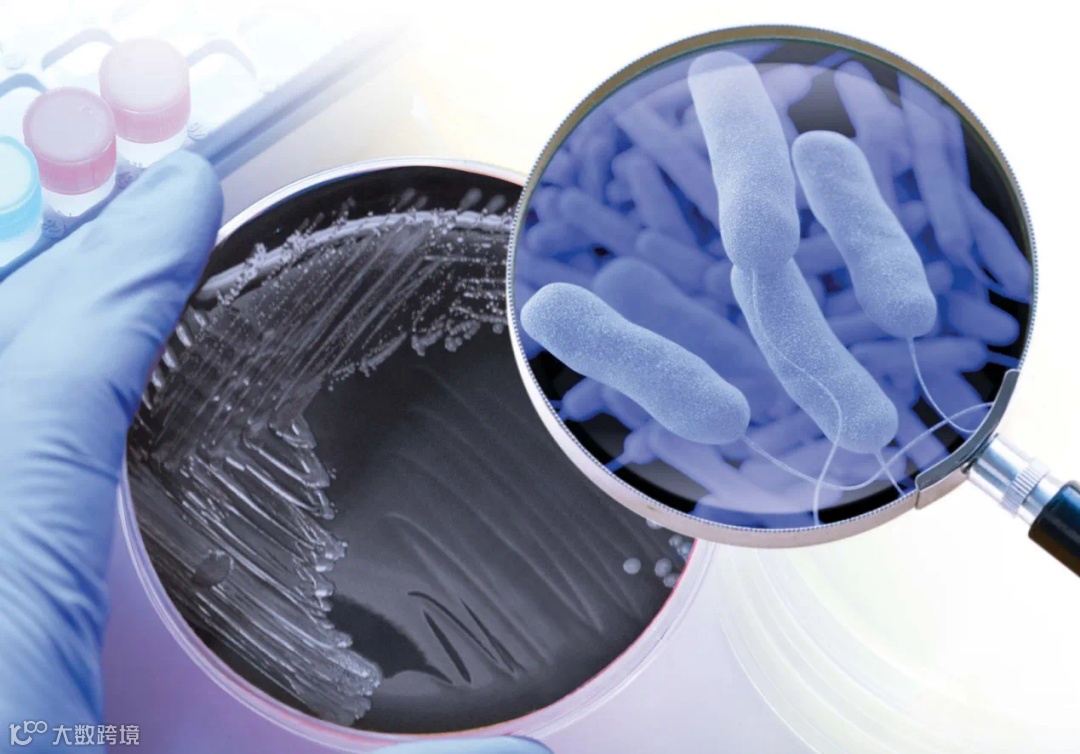

在连续几个月的降雨过后
深圳终于开启了“大火收汁”模式

大家纷纷表示

在这样难熬的夏天里
只有空调能“救我们一命”

但需要注意的是
长期未使用的空调
如果未经清洗就直接使用
可能会有“隐形杀手”藏于其中
随时准备“害人性命”!

都是空调惹的祸


近日,在长沙,市中心医院接连收治了两名军团菌肺炎患者,起病原因都与吹空调有关。
55岁的周先生(化名)因持续发热、寒战、咳嗽4天,住院接受治疗。询问病史得知,患者入院前启动了久未清洗的车载空调,每天在车上的时间超过10小时。不久后,就出现了类似“感冒”的症状。经诊断,患者感染了军团菌肺炎。
与周先生同一时间入院的还有32岁的姚女士(化名)。据她说,家中的空调已有半年多未曾清洗,入院前她在家使用了两天空调,一周后相继出现了咳嗽、咳痰、高热、寒战,以及呕吐、腹泻等症状,最终被确诊为重症军团菌肺炎。

👇👇👇
军团菌
又称为“退役军人杆菌”
属革兰氏阴性细菌
最喜欢温暖潮湿的环境
在25-42℃下可繁殖
广泛存在于自然、人工水环境中
军团菌肺炎的症状
军团菌肺炎侵入人体大约10天后发病,出现包括发热、咳嗽、咳痰、呼吸困难等类似感冒的症状,以及头痛、肌痛、腹泻、恶心、呕吐、横纹肌溶解、急性肾功能损害等多种肺外表现,严重者可导致休克甚至死亡。
千万不要小瞧了这种病菌!!
易感人群
中老年人、慢性心、肺、肾病等基础疾病患者、爱吸烟者及孕妇等。
大家一定要多加提醒身边的易感人群~
军团菌偏好炎热潮湿的环境
夏季是它繁殖的绝佳时机
如果不经常清洗空调
散热片及冷却水系统中
会积聚大量军团菌
当空调送风时
气溶胶形式的军团菌
被免疫力低下的人体吸入
就会导致军团菌肺炎
每年6月至9月都是军团菌肺炎的高发期


跟随深铁物业的步伐
一起来学习如何预防军团菌肺炎



希望大家都能
科学避暑、健康避暑
健健康康地度过每一个夏天~


内容来源:深铁物业、国家应急广播、央视一套
部分内容如有侵权联系删除
往期推荐
01 向心而行,携手与您通达美好生活!
02 奥林匹克日!深铁物业喊你一起来运动→
03 识别小标志,安全大不同!
04 夏季高温!这些空调消防安全常识要牢记!





